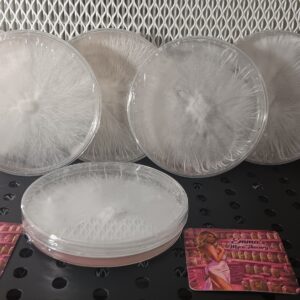
Milky Way Bundle (6 Plates)
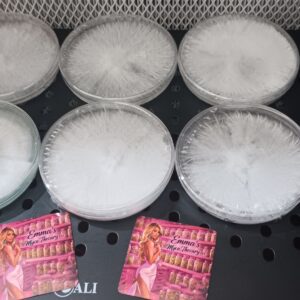
Space Bundle (6 Plates)
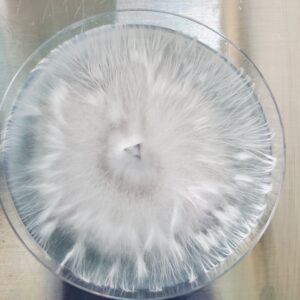
Shakti Uncut Research Plate 100mm
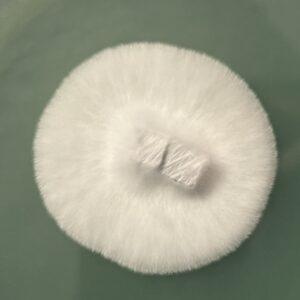
Toque X Flipper- Blob Mutation (90mm Research Plate)

Research
Showing 1–32 of 1921 resultsSorted by latest
-
See more products by: The Fungus Frequency
Psilocybe Ingeli Research Plate
Original price was: $35.00.$30.00Current price is: $30.00. -
See more products by: The Fungus Frequency
Psilocybe Ingeli Research Syringe
Original price was: $35.00.$30.00Current price is: $30.00. -
See more products by: Emma's Myco Thecary
Orissa India Research Plate
Original price was: $20.00.$10.00Current price is: $10.00. -
See more products by: Wildcrafted Remedies Mycology
Golden Envy Research Plate
$25.00 -
See more products by: Wildcrafted Remedies Mycology
El Choco Research Plate
$25.00 -
See more products by: Wildcrafted Remedies Mycology
Pink Buffalo Research Plate
$25.00 -
See more products by: Wildcrafted Remedies Mycology
Wild Oklahoma Research Plate
$25.00 -
See more products by: Marvelous Mikes Fungal Forge
Jedi Mind Fuck (JMF) Research Plate
Original price was: $15.00.$12.00Current price is: $12.00. -
See more products by: Marvelous Mikes Fungal Forge
Hawaiian (PES) Research Plate
Original price was: $15.00.$12.00Current price is: $12.00. -
See more products by: Marvelous Mikes Fungal Forge
Huatla Research Plate
Original price was: $15.00.$12.00Current price is: $12.00. -
See more products by: Monster Mycologist
Jack Frost Research Syringe
Original price was: $16.00.$15.00Current price is: $15.00. -
See more products by: Emma's Myco Thecary
Milky Way Bundle (6 Plates)
Original price was: $120.00.$55.00Current price is: $55.00. -
See more products by: Emma's Myco Thecary
Space Bundle (6 Plates)
Original price was: $120.00.$55.00Current price is: $55.00. -
See more products by: PsyTeam United
-
See more products by: PsyTeam United
-
See more products by: PsyTeam United
-
See more products by: PsyTeam United
-
See more products by: PsyTeam United
-
See more products by: PsyTeam United
-
See more products by: PsyTeam United
-
See more products by: BioTron Genetics
-
See more products by: BioTron Genetics
B+ 60ml Research Syringe
$40.00 -
See more products by: BioTron Genetics
-
See more products by: BioTron Genetics
-
See more products by: BioTron Genetics
-
See more products by: BioTron Genetics
-
See more products by: BioTron Genetics
-
See more products by: Mr. Mycelium
-
See more products by: RockyMountainFamilyMycology
F2 Texas Yellow Cap x Toque (Research Plate 90mm)
Original price was: $20.00.$16.00Current price is: $16.00. -
See more products by: Mad Mush
Makilla Gorilla Research Plate
Original price was: $20.00.$15.00Current price is: $15.00. -
See more products by: RockyMountainFamilyMycology
Toque X Flipper- Blob Mutation (90mm Research Plate)
Original price was: $20.00.$16.00Current price is: $16.00. -
See more products by: Mad Mush
Albino Saturn Tidepool Reasearch Plate
Original price was: $25.00.$20.00Current price is: $20.00.